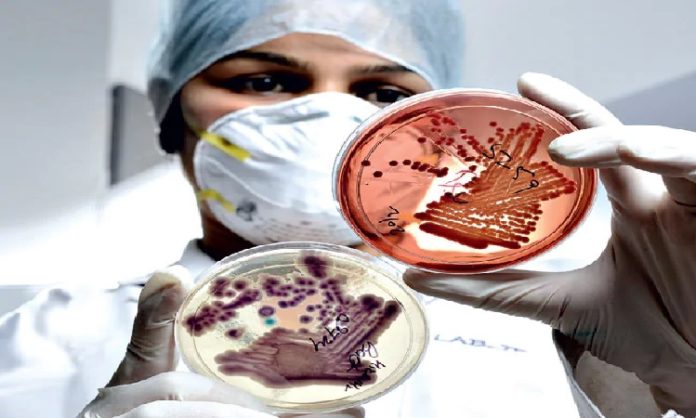

नई दिल्लीः SARS-COV-2 के खिलाफ उपचारात्मक एंटीबॉडीज (Remedial antibodies) के उत्पादन के प्रयास वैश्विक रूप से काफी तेज गति से जारी हैं। भारत में भी इन दिनों एक ऐसा ही प्रयास भारत सरकार के विज्ञान एवं प्रौद्योगिकी मंत्रालय में जैवप्रौद्योगिकी विभाग की सहायता से किया जा रहा है। इसे दिल्ली विश्वविद्यालय के साउथ कैंपस-सेंटर फार इनोवेशन इन इंफेक्शस डिजीज रिसर्च, एजुकेशन एंड ट्रेनिंग में प्रोफेसर विजय चैधरी के नेतृत्व में किया जा रहा है।
प्रोफेसर चैधरी का ग्रुप जीन्स इंकोडिंग एंटीबाडीज (Genes encoding antibodies) को पृथक कर रहा है, जो पहले से ही आंतरिक रूप से एवं ऐसे मरीजों जो कोविड 19 संक्रमण से ठीक हो चुके हैं, की कोशिकाओं से बने लाइब्रेरी से उपलब्ध बड़ी संख्या में एंटीबाडी लाइब्रेरी का उपयोग कर SARS-COV-2 को निष्प्रभावी बना सकते हैं।
Read also: मेक इन इंडियाः कोरोना वायरस के संक्रमण से बचाव के लिए कोहरे की बूंदों का उपयोग
इन एंटीबॉडी जीन्स (Antibodies genes) का उपयोग प्रयोगशाला में रिकाम्बीनेंट एंटीबॉडीज (Recombinant antibodies) का उत्पादन करने में किया जाएगा जो अगर वायरस को निष्प्रभावी करने में सफल रहे, तो इस वायरस के खिलाफ प्रोफिलैक्टिक (Prophylactic) एवं उपचारात्मक दोनों ही प्रकार से एंटीबाडीज (Antibodies) के सदाबहार स्रोत बन जाएंगे।
यह कार्य प्रोफेसर चैधरी के नेतृत्व एवं नेशनल इंस्टीच्यूट आफ इम्युनोलोजी के डा अमूल्या पांडा तथा जिनोवा बायोफार्मास्यूटिकल लिमिटेड (GBL), पुणे के डा संजय सिंह के सहयोग से एक कोविड रोधी संकाय के एक हिस्से के रूप में आरंभ किया जा रहा है।
Read also: कोरोना वायरस के खिलाफ लड़ाई में भारतीय रेलवे ने उठाए बड़े कदम
बता दें कोविड 19 सार्स कोरोना वायरस-2 (SARS-COV-2) द्वारा उत्पन्न होता है और इसका परिणाम कई मौतों के रूप में आ रहा है। हालांकि बड़ी संख्या में संक्रमित व्यक्ति बिना किसी विशिष्ट उपचार के भी ठीक हो रहे हैं। ऐसा वायरस के हमले की प्रतिक्रिया में शरीर के भीतर उत्पादित एंटीबाडीज के कारण होता है।
Read also: COVID-19 की जाँच के लिए पुणे स्थित स्टार्टअप तैयार कर रहा रैपिड डायग्नोस्टिक किट
पिछले कई वर्षों से संक्रमण से ठीक हो चुके कन्वलसेंट रोगियों के प्लाज्मा से प्राप्त एंटीबाडीज के निष्क्रिय हस्तांतरण का उपयोग डिपथिरिया, टिटनस, रैबीज एवं इबोला जैसी अनगिनत रोग स्थितियों के उपचार में किया गया है। आज ऐसे उपचारात्मक एंटीबाडीज को डीएनए आधारित रिकाम्बीनेंट प्रौद्योगिकियों द्वारा प्रयोगशाला में उत्पादित किया जा सकता है।